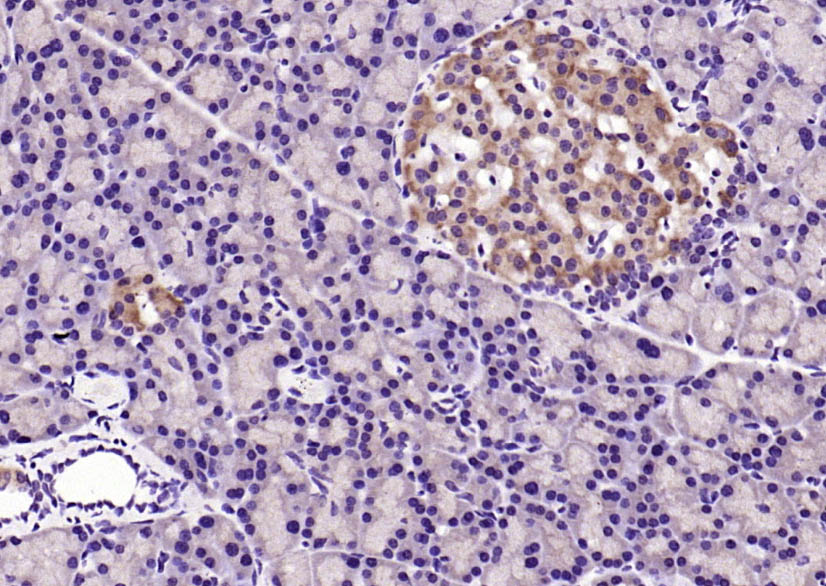
产品细节图片3

相关产品推荐更多 >

CCDC22 Rabbit pAb(bs-8124R)-50ul/100ul/200ul
¥1180
SOX9 Rabbit pAb, PE-Cy5.5 conjugated(bs-10725R-PE-Cy5.5)-100ul
¥2980
Collagen III Rabbit pAb, Biotin conjugated(bs-0948R-Bio)-100ul
¥2980
ENTPD2 Rabbit pAb, Biotin conjugated(bs-11515R-Bio)-100ul
¥2980
phospho-MDM2 (Ser166) Rabbit pAb, Biotin conjugated(bs-3266R-Bio)-100ul
¥2980
万千商家帮你免费找货
0 人在求购买到急需产品
- 详细信息
- 文献和实验
- 技术资料
- 应用范围:
产品信息以Bioss网站为准
- 规格:
50ul/100ul/200ul
| 规格: | 50ul | 产品价格: | ¥1180.0 |
|---|---|---|---|
| 规格: | 100ul | 产品价格: | ¥1980.0 |
| 规格: | 200ul | 产品价格: | ¥2800.0 |
| 产品编号 | bs-0172R |
| 英文名称 | IRS1 Rabbit pAb |
| 中文名称 | 胰岛素受体底物-1抗体 |
| 英文别名 | IRS1_HUMAN; Insulin receptor substrate 1; IRS-1; IRS 1; |
| 产品应用 | IHC-P=1:100-500, IHC-F=1:100-500, IF=1:100-300 Not yet tested in other applications. |
| 交叉反应 | Mouse, Rat (Human, Pig, Cow, Horse, Rabbit, Sheep) |
| 抗体来源 | Rabbit |
| 免疫原 | KLH conjugated synthetic peptide derived from rat IRS-1 |
| 亚型 | IgG |
| 性状 | Liquid |
| 纯化方法 | affinity purified by Protein A |
| 克隆类型 | Polyclonal |
| 理论分子量 | 137 kDa |
| 浓度 | 1mg/ml |
| 储存液 | 0.01M TBS (pH7.4) with 1% BSA, 0.02% Proclin300 and 50% Glycerol. |
| 研究领域 | Cancer > Signal transduction Cardiovascular > Atherosclerosis > Diabetes associated Metabolism > Types of disease > Cancer Metabolism > Types of disease > Diabetes Metabolism > Types of disease > Heart disease Metabolism > Types of disease > Obesity Neuroscience > Neurology process > Metabolism Signal Transduction > Adapters > Cytoplasmic Signal Transduction > Growth Factors/Hormones > Insulin / Insulin-like Tags & Cell Markers > Cell Type Markers > Tumor Associated |
| 亚基 | Interacts with UBTF and PIK3CA. Interacts (via phosphorylated YXXM motifs) with PIK3R1. Interacts with ROCK1 and FER. Interacts (via PH domain) with PHIP. Interacts with GRB2. Interacts with SOCS7. Interacts (via IRS-type PTB domain) with IGF1R and INSR (via the tyrosine-phosphorylated NPXY motif). Interacts with ALK. |
| 亚细胞定位 | IRS1 is predominantly found in the cytoplasm. Nuclear localization may occur in some cell types and under specific stimuli. |
| 组织特异性 | Isoform Long and isoform Short are predominantly expressed in tissue targets of insulin metabolic effects: liver, adipose tissue and skeletal muscle but are also expressed in the peripheral nerve, kidney, pulmonary alveoli, pancreatic acini, placenta vascular endothelium, fibroblasts, monocytes, granulocytes, erythrocytes and skin. Isoform Short is preferentially expressed in fetal cells such as fetal fibroblasts, muscle, liver and kidney. Found as a hybrid receptor with IGF1R in muscle, heart, kidney, adipose tissue, skeletal muscle, hepatoma, fibroblasts, spleen and placenta (at protein level). Overexpressed in several tumors, including breast, colon, lung, ovary, and thyroid carcinomas. |
| 翻译后修饰 | Serine phosphorylation of IRS1 is a mechanism for insulin resistance. Ser-312 phosphorylation inhibits insulin action through disruption of IRS1 interaction with the insulin receptor. Phosphorylation of Tyr-896 is required for GRB2-binding. |
| 相似性 | Contains 1 IRS-type PTB domain. Contains 1 PH domain. |
| 功能 | May mediate the control of various cellular processes by insulin. When phosphorylated by the insulin receptor binds specifically to various cellular proteins containing SH2 domains such as phosphatidylinositol 3-kinase p85 subunit or GRB2. Activates phosphatidylinositol 3-kinase when bound to the regulatory p85 subunit. |
| 保存条件 | Shipped at 4℃. Store at -20℃ for one year. Avoid repeated freeze/thaw cycles. |
| 注意事项 | This product as supplied is intended for research use only, not for use in human, therapeutic or diagnostic applications. |
| 背景资料 | Insulin receptor substrates (IRS) are responsible for several insulin related activities, such as glucose homeostasis, cell growth, cell transformation, apoptosis and insulin signal transduction. Serine/threonine phosphorylation of IRS1 has been demonstrated to be a negative regulator of insulin signaling and is responsible for its degradation, although IRS1 degradation pathways are not well understood. IRS1 has also been shown to be constitutively activated in cancers such as breast cancer, Wilm's tumors, and adrenal cortical carcinomas, thus making IRS1 phosphorylation and subsequent degradation an attractive therapeutic target. To date there have been four subtypes identified: IRS1, 2, 3 and 4, with IRS1 being widely expressed. |
| 应用 | 推荐稀释比例 |
| {IHC-P} | {1:100-500} |
| {IHC-F} | {1:100-500} |
| {IF} | {1:100-300} |

风险提示:丁香通仅作为第三方平台,为商家信息发布提供平台空间。用户咨询产品时请注意保护个人信息及财产安全,合理判断,谨慎选购商品,商家和用户对交易行为负责。对于医疗器械类产品,请先查证核实企业经营资质和医疗器械产品注册证情况。
文献和实验[IF={{ 7.129 }}] {Yanwen Hou. et al. Prenatal PM2.5 exposure contributes to neuronal tau lesion in male offspring mice through mitochondrial dysfunction-mediated insulin resistance. ECOTOX ENVIRON SAFE. 2022 Nov;246:114151} {WB} {Mouse}
[IF={{ 7.097 }}] {Yilan Shen et al. VEGF-B antibody and interleukin-22 fusion protein ameliorates diabetic nephropathy through inhibiting lipid accumulation and inflammatory responses.} {IHC} {mouse}
[IF={{ 7.097 }}] {Yilan Shen et al. VEGF-B antibody and interleukin-22 fusion protein ameliorates diabetic nephropathy through inhibiting lipid accumulation and inflammatory responses.} {Other} {}
[IF={{ 6.796 }}] {Tingting Ku. et al. Cardiac energy metabolism disorder mediated by energy substrate imbalance and mitochondrial damage upon tebuconazole exposure. J ENVIRON SCI-CHINA. 2022 Oct;:} {WB} {Mouse}
[IF={{ 6.691 }}] {Wang, Hongyan. et al. Protection of pancreatic β-cell by phosphocreatine through mitochondrial improvement via the regulation of dual AKT/IRS-1/GSK-3β and STAT3/Cyp-D signaling pathways. 2021 Aug 28} {WB} {Rat}
#:RT1510, HuaAn biotechnology , inc.4.IRS1, Mouse mAb IgG1, Cat#:M1210-2. HuaAn biotechnology , inc.5.XBP1, Rabbit polyclonal antibodies, SC-7160, Santa Cruz biotechnology,inc.6.b-Actin, Mouse monoclonal IgG1, SC-47778. Santa Cruz biotechnology
= NAL), appears to form upon oxidative cyclization of the nonfluorescent 2:1 lysine-HNE Michael adduct-Schiff base cross-link (Scheme 1). Polyclonal antibody (PAb) to the NAL-HNE fluorophore was raised in rabbit and found to be highly specific
分装 F0171 巨噬细胞趋化蛋白-2(MCP-2) ELISA 48T/96T 1500/2500 进口分装 F0172 巨噬细胞趋化蛋白-3(MCP-3) ELISA 48T/96T 1500/2500 进口分装 F0173 巨噬细胞来源的趋化因子(MDC/CCL22) ELISA 48T/96T 2000/3000 进口分装 F0174 干扰素-r 诱导单核细胞因子 (MIGF) ELISA 48T/96T 2000/3000 进口
技术资料暂无技术资料 索取技术资料






